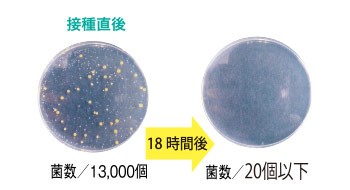

ポロシャツ[男女兼用](89-65621)


-安全・安心・清潔・快適-
「TioTioプレミアム」で24時間365日効果が持続!
ハイブリッド触媒TioTio プレミアムは、鉄イオン触媒の強力な酸化力を利用して悪臭や細菌類を破壊、分解する新しいタイプの抗菌・消臭機能剤です。 そのパワーを持続し強化するために鉄イオン触媒に常に酸化力を注入できるよう、 鉄と相性の良い希元素を極微量配合しました。 これにより、鉄イオン触媒の酸化還元反応がスムースに進行するため、広い範囲の 悪臭に対して安定的に消臭機能を発揮し、強い抗菌力が長期間持続します。
製品認証マークSEK
TioTioプレミアムの基本機能のうち、
「抗ウイルス」「抗菌」はSEKマークの認証を受けています。
抗ウイルス加工について
●抗ウイルス加工は、病気の治療や予防を目的とするものではありません●抗ウイルス性試験は、ウイルス株:ATCC VR-1679(エンベロープ有)、ATCC VR-782(エンベロープ無)を25℃で2時間放置して実施しています。
●抗ウイルス加工は、ウイルスの働きを抑制するものではありません。
ハイブリッド触媒抗ウイルス加工について
●ハイブリッド触媒TioTioはサンワード商会の登録商品です。●ハイブリッド触媒は大阪大学産業科学研究所との連携研究契約により生まれた多機能型触媒です。
TioTioプレミアム製品性能試験
抗ウイルス性【試験番号202119041127】
| 試験ウイルス株 | 洗濯10回後 抗ウイルス活性値 | ||||||||
|---|---|---|---|---|---|---|---|---|---|
| ATCC VR-1679(エンベロープ有) | 3.0 | ||||||||
| ATCC VR-782(エンベロープ無) | 3.8 |
抗菌性【試験番号20214020677】
| TioTioプレミアム加工布(洗濯10回後) | 未加工布 | ||||||||
|---|---|---|---|---|---|---|---|---|---|
![]() |
![]() |
消臭性【試験番号20214021011】
全ての成分でニオイが90%以上減少!! |
防汚性【試験番号20215001923】
どんな汚れが付いても安心! |
安全性
素肌に触れても安心安全! |
帯電性【試験番号20215004043-1】
未加工品と比べて、静電気が溜まりにくい! |
洗濯耐久性
抗菌試験消臭試験
TioTioプレミアム加工が施された布・商品を洗濯し、それぞれの試験を行いました。洗濯前・洗濯後ともにほぼ同じ試験結果となり、洗濯後も効果が持続することが証明されました。 半永久的に効果が持続! |
商品詳細Detail
「抗ウイルス」「制菌加工」2つの強力なウイルス対策
抗ウイルス加工「ハイブリッド触媒TioTioプレミアム」を施したニット素材。さらに「工業洗濯耐」にも対応しており丈夫な高機能素材です。


スラッシュ縦ポケット
縦口仕様でネームホルダーや鍵がさっとしまえて落ちにくい。第一ボタンがないので涼しく着ることができます。後ろ長め丈
ヒップがすっぽり隠れるので、腰まわりのシルエットも気にならない。

男女別のシルエット
男性も女性も働く職場だから、ユニセックスでありながらS/SSサイズは女性の体型をベースにした別シルエットになります。



カラーバリエーションColor variation
ネイビーxホワイト(65621) |
ネイビー(65641) |
サックス(65642) |
ピンク(65643) |
商品説明Description
ニット素材で動きやすく、工業洗濯にも対応している優秀ポロ。働く人のことを考えた機能が充実していて、ボタンまわりの配色と第一ボタンのないデザインが印象的です。TioTioプレミアム加工もついていて、毎日のケアワークも安心です。
- 商品番号
- 89-65621
- 素材
- ポリエステル100%
- 仕様
- スラッシュ縦ポケット、後ろ長め丈、第一ボタンがない涼しいデザイン、比翼仕様
- 機能
- TioTio プレミアム清潔加工、工業洗濯対応、ニット、吸汗、速乾、制電、裏点接触 (※ネイビーホワイトは、制電と裏点接触の機能がありません)
サイズ詳細
| サイズ | SS | S | M | L | LL | 3L | 4L |
|---|---|---|---|---|---|---|---|
| 胸囲 | 90 | 96 | 102 | 108 | 114 | 122 | 130 |
| 肩幅 | 36 | 38 | 41 | 44 | 46 | 48 | 50 |
| 着丈 | 61 | 64 | 67 | 70 | 73 | 73 | 73 |
| 袖丈 | 22 | 22 | 23 | 24 | 25 | 26 | 26 |
シリーズ商品Series item
商品を選択する
この商品を購入された方のレビュー
- 2025/09/22
- ゆみんさん
- 性別:女性
- 身長:158cm
- 体重:55kg台
- 普段着用するサイズ:L
- 購入したサイズ:L
- 2022/11/16
- Toshiさん
- 性別:女性
- 身長:157cm
- 体重:50kg台
- 普段着用するサイズ:S
- 購入したサイズ:S
胸ポケットが深く気に入っています。
胸囲・胴囲にも余裕があって楽です。
- 2022/05/05
- さん
- 普段着用するサイズ:M
- 購入したサイズ:M
カラー違いで素材が違うことに、両方着てから気がつきました!
どちらも良いです。

まだ着用していないため、わかりません